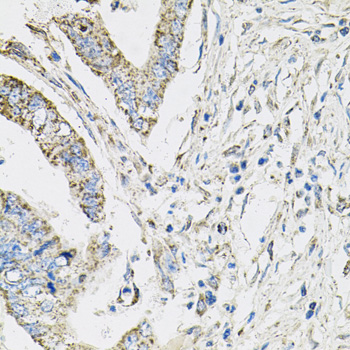
Immunohistochemistry - PI3 Kinase p110 beta Polyclonal Antibody

-
Product Name
PI3 Kinase p110 beta Polyclonal Antibody
- Documents
-
Description
Polyclonal antibody to PI3 Kinase p110 beta
-
Tested applications
WB, IHC, IF
-
Species reactivity
Human, Mouse, Rat
-
Alternative names
PIK3CB antibody; P110BETA antibody; PI3K antibody; PI3KBETA antibody; PIK3C1 antibody; phosphatidylinositol-4,5-bisphosphate 3-kinase catalytic subunit beta antibody
-
Isotype
Rabbit IgG
-
Preparation
Antigen: Recombinant fusion protein containing a sequence corresponding to amino acids 771-1070 of human PI3 Kinase p110 beta (NP_006210.1).
-
Clonality
Polyclonal
-
Formulation
PBS with 0.02% sodium azide, 50% glycerol, pH7.3.
-
Storage instructions
Store at -20℃. Avoid freeze / thaw cycles.
-
Applications
WB 1:500 - 1:2000
IHC 1:50 - 1:100
IF 1:50 - 1:100 -
Validations

Western blot - PI3 Kinase p110 beta Polyclonal Antibody
Western blot analysis of extracts of various cell lines, using PI3 Kinase p110 beta antibody at 1:1000 dilution.Secondary antibody: HRP Goat Anti-Rabbit IgG (H+L) at 1:10000 dilution.Lysates/proteins: 25ug per lane.Blocking buffer: 3% nonfat dry milk in TBST.Detection: ECL Enhanced Kit .Exposure time: 90s.

Immunohistochemistry - PI3 Kinase p110 beta Polyclonal Antibody
Immunohistochemistry of paraffin-embedded mouse lung using PI3 Kinase p110 beta antibody at dilution of 1:100 (40x lens).

Immunohistochemistry - PI3 Kinase p110 beta Polyclonal Antibody
Immunohistochemistry of paraffin-embedded human lung using PI3 Kinase p110 beta antibody at dilution of 1:100 (40x lens).
Immunohistochemistry - PI3 Kinase p110 beta Polyclonal Antibody
Immunohistochemistry of paraffin-embedded human colon carcinoma using PI3 Kinase p110 beta antibody at dilution of 1:100 (40x lens).
-
Background
Phosphoinositide-3-kinase (PI3K) that phosphorylates PtdIns (Phosphatidylinositol), PtdIns4P (Phosphatidylinositol 4-phosphate) and PtdIns(4,5)P2 (Phosphatidylinositol 4,5-bisphosphate) to generate phosphatidylinositol 3,4,5-trisphosphate (PIP3). PIP3 plays a key role by recruiting PH domain-containing proteins to the membrane, including AKT1 and PDPK1, activating signaling cascades involved in cell growth, survival, proliferation, motility and morphology. Involved in the activation of AKT1 upon stimulation by G-protein coupled receptors (GPCRs) ligands such as CXCL12, sphingosine 1-phosphate, and lysophosphatidic acid. May also act downstream receptor tyrosine kinases. Required in different signaling pathways for stable platelet adhesion and aggregation. Plays a role in platelet activation signaling triggered by GPCRs, alpha-IIb/beta-3 integrins (ITGA2B/ ITGB3) and ITAM (immunoreceptor tyrosine-based activation motif)-bearing receptors such as GP6. Regulates the strength of adhesion of ITGA2B/ ITGB3 activated receptors necessary for the cellular transmission of contractile forces. Required for platelet aggregation induced by F2 (thrombin) and thromboxane A2 (TXA2). Has a role in cell survival. May have a role in cell migration. Involved in the early stage of autophagosome formation. Modulates the intracellular level of PtdIns3P (Phosphatidylinositol 3-phosphate) and activates PIK3C3 kinase activity. May act as a scaffold, independently of its lipid kinase activity to positively regulate autophagy. May have a role in insulin signaling as scaffolding protein in which the lipid kinase activity is not required. May have a kinase-independent function in regulating cell proliferation and in clathrin-mediated endocytosis. Mediator of oncogenic signal in cell lines lacking PTEN. The lipid kinase activity is necessary for its role in oncogenic transformation. Required for the growth of ERBB2 and RAS driven tumors.
Related Products / Services
Please note: All products are "FOR RESEARCH USE ONLY AND ARE NOT INTENDED FOR DIAGNOSTIC OR THERAPEUTIC USE"
